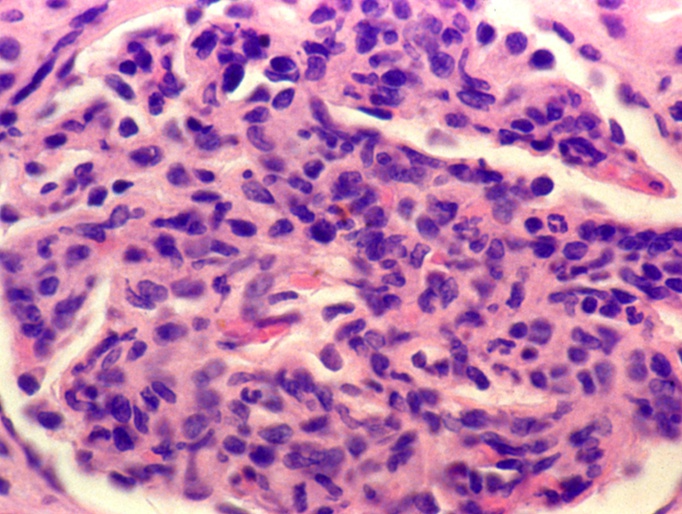

17 Nephritic Syndrome
Pathogenesis and Symptoms
_..



_..

increased hydrostatic pressure in rest of body
GFR low: The glomeruli are stuffed full of cells, and blood flow slows way down.


uremia: aka azotemia
Causes
_..

membranoproliferative: either nephritic or nephrotic
PSGN
_..


deplete complements

rheumatic fever: master chef with M
PSGN: post strep glomerulonephritis: chef on phone
Facial puffs: Facial swelling seen in PSGN
Cola: Cola colored urine with PSGN
Calendar: PSGN occurs 2 weeks after Strep infection
Pencil: Early penicillin for treatment (prevents RF but not PSGN). Even though chef has pencil, he still has symptoms
_..
PSGN, lupus, MPGN
_..

takes time for immune system
_..

hypercellular: inflammation related


bumpy appearance because in endothelium



worked their way into sub epithelium
_..


IgA
_..


_..

IgA usually does not activate complement but does here
weak complement activation, thus no hypocomplementemia
_..


IgA stain, like branches of tree
HS Purpura
_..

IgA deposition in joints, GI
IF stain granular

complement activated via alternative/lectin pathway. IgA does not fix complement


biopsy shows IgA deposition
DPGN
_..

type 1/2: mild; 3-5 serious
focal: <50% glomerulus involved
_..



immune response from anti-dsDNA

_..

can be nephrotic, nephritic
RPGN
_..



RPGN: common pattern of inflammation in glomeruli representing many diseases
quickly progress to RF


elevated BUN:Cr
_..


RPGN Type I
_..




not bumpy


RPGN Type II
_..



RPGN type III
_..

Pauci-immune: no immune staining


Alport
_..

male child with triad
Electron microscopy of a renal biopsy shows irregular thinning of the glomerular basement membrane (GBM) with splitting/lamination of the lamina densa, giving the GBM a unique “basketweave” appearance.

Last updated